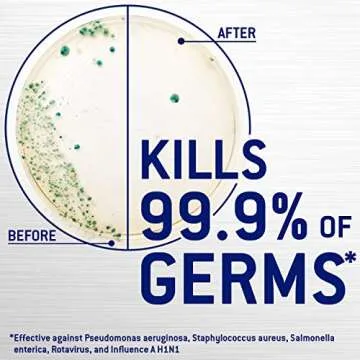
Microban 24 Hour Cleaner - Powerful Antimicrobial Spray

Microban 24 Hour Bathroom Cleaner & Sanitizing Spray - Fresh Citrus Scent (Pack of 2)
- 53
- 0
- 100+ Sold in the past week
- 💥 300+ people added this to wishlists
- ⏳ Limited quantity — order now
- 📈 Top-rated choice






 Bathroom Storage & Organization
Bathroom Storage & Organization
 Laundry Storage & Organization
Laundry Storage & Organization
 Kitchen Storage & Organization
Kitchen Storage & Organization
 Clothing & Wardrobe Storage
Clothing & Wardrobe Storage
 Storage Baskets
Storage Baskets
 Storage Bags
Storage Bags
 Air Vacuum Bags
Air Vacuum Bags
 Portable Storage
Portable Storage
 Vacuum Bag Pumps
Vacuum Bag Pumps
 Portable Shopping Carts
Portable Shopping Carts
 Storage Holders & Racks
Storage Holders & Racks
 Storage Drawers
Storage Drawers
 Storage Boxes & Bins
Storage Boxes & Bins
 Storage Bottles & Jars
Storage Bottles & Jars
 Statues, Miniatures
Statues, Miniatures
 Decorative Accessories
Decorative Accessories
 Photo Frames, Boards
Photo Frames, Boards
 Clock
Clock
 Wind Chimes, Hanging Decorations
Wind Chimes, Hanging Decorations
 Painting, Calligraphy
Painting, Calligraphy
 Flags
Flags
 Banners, Accessories
Banners, Accessories
 Music Boxes
Music Boxes
 Candles, Holders
Candles, Holders
 Door Sticker
Door Sticker
 Christian Decor
Christian Decor
 Wall Stickers
Wall Stickers
 Flower Pots
Flower Pots
 Decorative Mirrors
Decorative Mirrors
 Plates, Signs
Plates, Signs
 Bedside Lamp, Lampshade
Bedside Lamp, Lampshade
 Decorative Lamp
Decorative Lamp

Introducing the Microban 24 Hour Bathroom Cleaner and Sanitizing Spray - your essential partner for maintaining a pristine and safe environment in your home! This powerful cleaner features a unique antimicrobial formula that actively inhibits the growth of bacteria, mold, and mildew, making cleaning not just effective but also crucial for a hygienic living space. With its delightful fresh citrus scent, each spray transforms your cleaning routine into a refreshing...
Show moreIntroducing the Microban 24 Hour Bathroom Cleaner and Sanitizing Spray - your essential partner for maintaining a pristine and safe environment in your home! This powerful cleaner features a unique antimicrobial formula that actively inhibits the growth of bacteria, mold, and mildew, making cleaning not just effective but also crucial for a hygienic living space. With its delightful fresh citrus scent, each spray transforms your cleaning routine into a refreshing experience.
Manufactured by Microban, a name synonymous with quality in home sanitation, this cleaner is highly effective on various surfaces such as countertops, bathrooms, and hardwood floors. Users have lauded its ability to tackle tough messes, ensuring that surfaces not only shine but remain free from stains or discoloration. Furthermore, the easily manageable 32-ounce spray bottles provide ample usage, making it a practical choice for every household, especially those with children or pets.
Each bottle is designed with a focus on convenience and durability, ensuring the quality of the product remains intact during shipment. However, it is advisable to handle with care to avoid any potential leakage issues during transit. While feedback has indicated some minor packaging concerns, rest assured that the performance of this cleaner has garnered high marks from users who've shared their satisfaction with its cleaning capabilities and lingering scent.
Incorporate the Microban Antimicrobial Cleaner into your daily cleaning regimen, and enjoy peace of mind knowing that your home is not just clean but is also protected against unwanted microbial growth for extended periods. Choose Microban for a cleaner, fresher home that prioritizes your family’s health and hygiene.
Less| weight | 2 |
|---|---|
| size | 32 Fl Oz (Pack of 2) |
| productGroup | Drugstore |
Yes, the Microban cleaner is designed to be safe for use around pets when used as directed.
It is effective on a variety of surfaces including countertops, floors, and bathrooms.
No, users report that it cleans effectively without leaving any stains or residue.
Microban provides lasting protection against bacteria and mold, making it a great choice for ongoing sanitization.

 Giftpals.com
Giftpals.com

